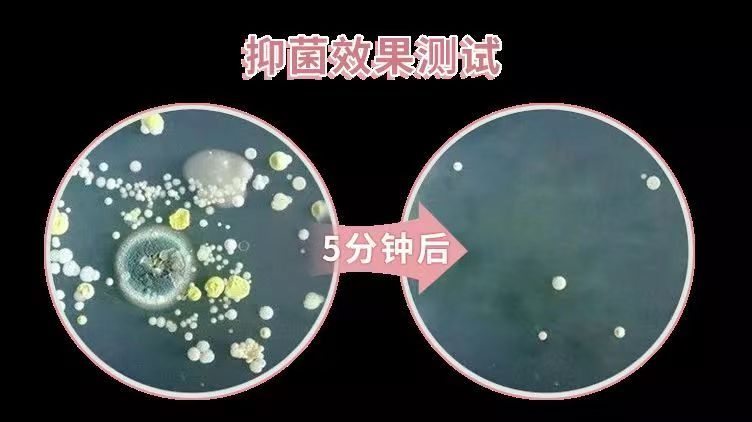

商品详情
内衣宝藏清洁洗衣液,山姆同款79元一瓶。
一瓶多效=抑菌+除菌+香软+护色+温和,安全𝟎添加。
天然成分抑菌𝟗𝟗% 小分子瓦解污渍。
活性蛋白酶+多重植物成分强强联手。
集团拥有多项专利!产品质量真的非常好!
















✅适用于多重材质,温和守护秘处健康
✅长效抑菌、温和清洁、去除异味、植物配方
✅99%除菌率,定向去除顽固污渍。内衣裤专用洗衣液,温和洗护不伤手。

- 贝贝成衣秀儿200927 (微信公众号认证)
- 爱自己~看得见的美~
- 扫描二维码,访问我们的微信店铺
- 随时随地的购物、客服咨询、查询订单和物流...